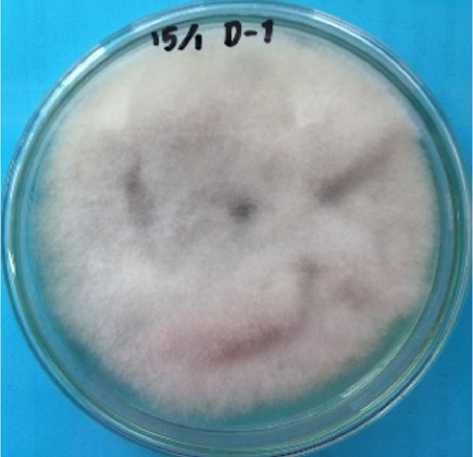

Aktivitas Sitotoksik dan Antibakteri Ekstrak Etil Asetat Jamur Endofitik Colletotrichum gloeosporioides
on

JURNAL FARMASI UDAYANA | pISSN: 2301-7716; eISSN: 2622-4607 | VOL. 10, NO. 2, 2021
https://doi.org/10.24843/JFU.2021.v10.i02.p15
Aktivitas Sitotoksik dan Antibakteri Ekstrak Etil Asetat Jamur Endofitik Colletotrichum gloeosporioides yang Diisolasi dari Daun Artocarpus heterophyllus
Riga Riga1 and Euis Holisotan Hakim2
-
1 Jurusan Kimia, Fakultas Matematika dan Ilmu Pengetahuan Alam, Universitas Negeri Padang, Jalan Prof. Dr. Hamka, Air Tawar Barat, Padang 25132
-
2 Kelompok Keahlian Kimia Organik, Program Studi Kimia, Fakultas Matematika dan Ilmu Pengetahuan Alam, Institut Teknologi Bandung, Jalan Ganesha 10, Bandung 4011
Reception date of the manuscript: 13 Maret 2021 Acceptance date of the manuscript: 23 Mei 2021 Publication date: 31 Desember 2021
Abstract— Artocarpus heterophyllus is reported to produce secondary metabolites with various biological activities, including antibacteria and citotoxicity. Further exploration of bioactive compounds from A. heterophyllus can also be conducted by advanced technologies such as developing culture of its endophytic fungi. The purpose of this research was to study the cytotoxic and antibacterial activity of the ethyl acetate (EtOAc) extract from fungus Colletotrichum gloeesporioides colonized with leaves of A. heterophyllus. The steps of this research were isolation, cultivation of endophytic fungus from leaves of A. heterophyllus followed by liquid-liquid extraction, cytotoxic and antibacterial testing, and phytochemical screening of ethyl acetate extract of fungus C. gloeosporioides derived from leaves of A. heterophyllus. MTT (3-[4,5-dimethylthiazol-2-yl]-2,5 diphenyl tetrazolium bromide) assay was used for cytotoxic activity against murine leukemia P-388 cells. Disc difussion method for antibacterial activity against four tested bacteria, Enterococcus faecalis, Staphylococcus saprophyticus, Salmonella enterica, and Citrobacter freundii. The results of cytotoxicity showed that the EtOAc extract of C. gloeosporioi-des was active against murine leukemia P-388 cells with an IC50 value of 18.97 µg/mL. EtOAc extract was also active to inhibit the growth of all tested bacteria with an inhibition zone ranging from 4.3 -14.3 mm. Research about to the study of the cytotoxic and antibacterial activity of C. gloeosporioides in leaves of A. heterophyllus is reported for the first time.
Keywords—Artocarpus heterophyllus,Colletotrichum gloeosporioides, antibacterial, cytotoxic
Abstrak— Artocarpus heterophyllus merupakan salah satu tumbuhan yang dilaporkan menghasilkan beragam metabolit sekunder yang bersifat sitotoksik dan antibakteri. Selain melakukan studi kimia terhadap tumbuhan alaminya, eksplorasi terkait kajian fitokimia tumbuhan ini dapat dilakukan terhadap jamur endofitik yang berkolonisasi dengan tumbuhan A. heterophyllus. Tujuan penelitian ini adalah melakukan uji aktivitas sitotoksik dan antibakteri ekstrak etil asetat (EtOAC) jamur Colletotrichum gloeesporioides yang berkolonisasi dengan daun A. heterophyllus. Tahapan dari penelitian ini terdiri dari inokulasi, sub-kultur, kultivasi jamur endofitik yang dilanjutkan dengan ekstraksi, uji aktivitas sitotoksik dan antibakteri serta skrinning fitokimia dari ekstrak etil asetat jamur C. gloeosporioides yang diisolasi dari daun A. heterophyllus. Metode MTT (3-[4,5-dimethiltiazol-2-il]-2,5 difenil tetrazolium bromida) digunakan untuk uji aktivitas sitotoksik terhadap sel murin leukemia P-388. Metode difusi cakram untuk pengujian aktivitas antibakteri terhadap empat baketri uji, yaitu Enterococcus faecalis, Staphylococcus saprophyticus, Salmonella enterica, dan Citrobacter freundii. Hasil uji sitotoksik menunjukkan bahwa ekstrak EtOAc jamur C. gloeosporioides bersifat aktif terhadap sel murin leukemia P-388 dengan nilai IC50 18,97 µg/mL. Hasil uji antibakteri juga menunjukkan bahwa ekstrak EtOAc mempunyai kemampuan dalam menghambat pertumbuhan semua bakteri uji dengan rentang zona hambat 4,3 – 14,3 mm. Kajian sifat sitotoksik dan antibakteri dari jamur C. gloeosporioides yang hidup pada daun A. heterophyllus baru pertama kali dilakukan pada kesempatan ini.
Kata Kunci—Artocarpus heterophyllus,Colletotrichum gloeosporioides, antibakteri, sitotoksik
Penulis koresponden: Riga, rigakimia@fmipa.unp.ac.id
Artocarpus heterophyllus merupakan salah satu spesies penting dalam famili Moraceae. Secara tradisional, tumbuhan yang dikenal dengan nama nangka ini telah banyak dimanfaatkan untuk menyembuhkan peradangan, demam, malaria dan diare ((Jagtap & Bapat, 2010; Ranasinghe et al.,
-
2019) . Kajian fitokimia tumbuhan ini menunjukkan bahwa A. heterophyllus menghasilkan senyawa fenolik dengan ciri khas terprenilasi seperti flavonoid, stilben dan 2-arilbenzofuran dengan beragam fungsi farmakologis seperti sitotoksik, antimikroba, anti malaria dan anti oksidan (Ach-mad et al., 2002; Daus et al., 2017). Beragam laporan tersebut menunjukkan bahwa A. heterophyllus merupakan salah satu tumbuhan yang potensial menghasilkan berbagai senyawa bioaktif. Eksplorasi lebih lanjut terkait sumber alternatif senyawa bioaktif dari A. heterophyllus dapat dilakukan dengan teknologi yang mutakhir antara lain teknik kultur jamur endofitik.
Jamur endofitik adalah jamur yang hidup dalam jaringan tumbuhan, seperti akar, bunga, daun, buah, dan ranting secara berkolonisasi (Manganyi & Ateba, 2020; Patil et al., 2016; Riga et al., 2019c). Interaksi antara jamur endofitik dengan tumbuhan inangnya merupakan hubungan yang saling menguntungkan. Jamur endofitik akan menghasilkan beragam metabolit sekunder yang dapat memproteksi tumbuhan inangnya dalam menghadapi situasi ekstrim (Manganyi & Ateba, 2020; Yu et al., 2019). Golongan metabolit sekunder yang telah berhasil diisolasi dari jamur endofitik antara lain alkaloid, steroid, terpenoid, dan senyawa turunan fenolik. Senyawa tersebut dilaporkan mempunyai beragam bioaktivitas, termasuk sitotoksik dan antibakteri (Khiralla et al., 2020; Qu et al., 2020; Ranasinghe et al., 2019).
Keragaman dan distribusi jamur endofitik yang hidup dalam spesies tumbuhan A. heterophyllus telah pernah dilaporkan sebelumnya (Manoharachary & Nagaraju, 2016). Laporan lain menunjukkan adanya aktivitas antibakteri dan sito-toksik dari ekstrak dan senyawa yang diperoleh dari ekstrak etil asetat (EtOAc) jamur endofitik yang berasosiasi dengan berbagai tumbuhan Artocarpus (Riga et al., 2019a,b,c). Berdasarkan hal tersebut, tujuan penelitian ini adalah menguji aktivitas sitotoksik dan antibakteri dari ekstrak EtOAc jamur endofitik C. gloeosporioedes yang diisolasi dari daun tumbuhan A. heterophyllus.
Alat-alat yang digunakan pada tahapan inokulasi dan kultivasi jamur endofitik adalah cawan petri, laminar air flow (BOF), pinset, pisau bedah, bunsen, inkubator, erlenmeyer, jarum ose, serta autoklaf, corong pisah, corong Büchner, kertas saring, pompa vakum, dan rotary evaporator(BUCHI-R-114). Bahan-bahan yang digunakan pada tahap isolasi dan kultivasi jamur endofitik adalah akuades, etanol teknis, natrium hipoklorit, Potato Dextrose Agar (PDA, Himedia) dan Potato Dextrose Broth (PDB, Himedia). Analisis metabolit sekunder pada ekstrak etil asetat dilakukan dengan teknik kromatografi lapis tipis (KLT) menggunakan silika gel Merck 60 Kiesel F254 dengan ketebalan 0,25 mm. Untuk analisis hasil KLT digunakan pereaksi penampak noda cerium sulfat. Senyawa artonin E digunakan sebagai kontrol positif dalam uji sitotoksik terhadap sel murin leukemia P388, sedangkan ciprofloxacin digunakan sebagai kontrol positif dalam uji aktivitas antibakteri. Empat bakteri uji klinis, yaitu E. faecalis, S. saprophyticus, S. enterica, and C. freun-dii diperoleh dari laboratorium kimia bahan alam, Institut Teknologi Bandung.
Daun tumbuhan A. heterophyllus yang diperoleh dari taman Sekolah Farmasi, Institut Teknologi Bandung dipotong menjadi berukuran 2 × 2 cm. Proses sterilisasi, inokulasi dan kultivasi jamur endofitik mengikuti prosedur yang telah dilaporkan sebelumnya (Riga et al., 2019a). Daun dialiri dengan air bersih untuk membersihkan permukannya. Daun selanjutnya disterilasi permukaannya menggunakan larutan etanol 70% selama 45 detik dan larutan NaOCl 3,5 % selama 30 detik. Daun steril ditempelkan pada media padat PDA sebagai kontrol negatif. Kemudian daun dipotong menjadi berukuran 1 × 1 cm untuk diinokulasi di atas media padat PDA dan diinkubasi pada suhu 280°C. Setelah 7 hari, jamur endofitik yang tumbuh di sub-kultur ke media padat lainnya sehingga diperoleh isolat tunggal jamur endofitik.
Isolat tunggal jamur endofitik diidentifikasi berdasarkan analisis genetika pada daerah Internal Transcribed Spacer (ITS) ribosomal DNA (rDNA) (Riga et al., 2019c). Isolat tunggal jamur dikarakterisasi di Indonesian Culture Collection (InaCC), Lembaga Ilmu Pengetahuan Indonesia (LIPI), Cibinong.
Isolat tunggal jamur dimasukkan ke dalam enam erlenme-yer 250 mL yang berisi 50 mL media cair PDB (konsentrasi 24 g PDB/L akuades). Dua erlenmeyer dari fermentasi jamur tersebut masing-masing dipanen pada minggu kedua, ketiga dan keempat untuk menentukan waktu optimum kultivasinya. Media hasil fermentasi diekstraksi dengan etil asetat dan kemudian dipekatkan dengan rotary evaporator sehingga didapatkan ekstrak etil asetat dari masing-masing jamur. Berdasarkan massa dan profil KLT masing-masing ekstrak tersebut dapat diketahui waktu kultivasi optimum jamur en-dofitik dalam memproduksi metabolit sekunder. Jamur endo-fitik dikultivasi dalam skala besar pada media cair PDB untuk mendapatkan ekstrak dalam jumlah lebih banyak. Setelah waktu kultivasi optimumnya, miselia dipisahkan dari media cairnya menggunakan corong Büchner. Media cairnya dipar-tisi dengan etil asetat sebanyak tiga kali dengan corong pisah. Fasa organiknya kemudian dipisahkan dan diuapkan dengan evaporator sehingga didapatkan ekstrak etil asetat. Ekstrak EtOAc yang diperoleh akan digunakan untuk uji kandungan metabolit sekunder dan uji aktivitas antibakteri serta sitotok-sik.
Uji aktivitas antibakteri dari ketiga ekstrak jamur endo-fitik dilakukan dengan menggunakan metode diusi cakram (Riga et al., 2019c). Aktivitas antibakteri dinyatakan dengan zona hambat dalam mm. Pengujian zona hambat bakteri ini dilakukan sebanyak tiga kali (triplo) terhadap empat bakteri, yaitu E. faecalis, S. saprophyticus, S. enterica, and C. freun-dii. Kontrol positif yang digunakan pada pengujian sifat anti mikroba ini adalah ciprofloxacin 5 g/mL. Pengerjaan uji an-tibakteri dilakukan di laboratorium kimia bahan alam, program studi Kimia, ITB.
Ektrak EtOAc diuji sifat sitotoksiknya terhadap sel mu-rin leukemia P-388 menggunakan metode MTT. Pengerjaan uji sitotoksik dilakukan sebanyak satu kali di laboratorium kimia bahan alam, program studi Kimia, ITB. Aktivitas si-totoksik dinyatakan dengan IC50 dengan artonin E sebagai kontrol positif (Sahidin et al., 2005).
Tabel 1: MASSA EKSTRAK ETOAC (MG) PADA MINGGU pertama, kedua, ketiga, dan keempat.
|
Jamur |
Minggu Pertama |
Minggu Kedua |
Minggu Ketiga |
Minggu Keempat |
|
12,6 mg |
32,4 mg |
33,9 mg |
34,6 mg |
Gambar. 1: Isolat tunggal jamur endofitik C. gloeosporioides dari daun A. heterophyllus
Ekstrak EtOAc dimasukkan ke dalam tabung reaksi dan kemudian ditambahkan amoniak-kloroform dan H2SO4 2 N. Campuran ini dikocok dengan kuat dan didiamkan hingga terbentuk dua lapisan. Lapisan bawah dipindahkan ke plat tetes, dibiarkan menguap dan ditambahkan asam asetat anhi-drat dan H2SO4 p.a.
Lapisan atas pada uji seroid/terpenoid diatas dimasukkan ke dalam tiga tabung reaksi. Ke dalam masing-masing tabung reaksi ditambahkan pereaksi Dragendorf, pereaksi Mayer dan pereaksi Wagner secara berurutan. Hasil positif uji alkaloid pada ketiga pereaksi memberikan endapan coklat, endapan putih dan endapan jingga.
Ekstrak EtOAc dimasukkan ke dalam plat tetes dan ditambahkan larutan FeCl3 1 %. Hasil positif senyawa fenolik memberikan warna merah muda.
Dilakukan pengamatan terhadap massa ekstrak EtOAc C. gloeosporioides secara berkala yaitu sampai minggu ke empat (Tabel 1). Kemudian dilakukan pengamatan terhadap kemampuan zona hambar ekstrak pada konsetrasi 1-3 % (Tabel 2). Tahap selanjutnya adalah menentukan nilai IC50 esk-trak ((Tabel 3) dan mengidentifikasi kandungan senyawa dalam esktrak ((Tabel 4). Metabolit selunder ekstrak EtOAc jamur C. gloeosporioides adalah alkaloid, terpenoid, dan feno-lik.
Tujuan dari penelitian ini adalah mengidentifiksi aktivitas sitotoksik dan antibakteri dari ekstrak etil asetat (EtOAc) jamur endofitik yang diisolasi dari daun tumbuhan A. hete-rophyllus yang berpotensi sebagai lead compound senyawa obat. Pemanfataan berbagai bagian tumbuhan A. heterophy-llus untuk mengobati beragam jenis penyakit merupakan faktor yang melandasi pemilihan sampel pada riset ini. Fakta menunjukkan bahwa sifat etnofarmokologi suatu tumbuhan dipengaruhi oleh kandungan senyawa biokatif yang terdapat pada tumbuhan tersebut. Kajian fitokimia lebih lanjut dari tumbuhan A. heterophyllus dapat dilakukan terhadap jamur endofitik yang berasosiasi dengan tumbuhan ini. Penelitian terkait aktivitas sitotoksik dan antibakteri terhadap ekstrak organik dan senyawa murni dari jamur endofitik yang bera-sosisasi dengan berbagai tumbuhan telah pernah dilaporkan sebelumnya. Akan tetapi, kajian aktivitas biologis dari ekstrak EtOAc jamur endofitik pada daun A. heterophyllus untuk pertama kalinya dipublikasikan pada kesempatan ini. Pelarut EtOAc digunakan pada penelitian karena bersifat semi polar sehingga dapat maksimal mengekstraksi metabolit sekunder yang terkandung dalam jamur endofitik (Riga et al., 2019b).
Tahap awal pada penelitian ini adalah mengisolasi jamur endofitik dari bagian daun tumbuhan A. heterophyllus. Daun A. heterophyllus dicuci bersih menggunakan air mengalir untuk mengeliminasi pengotor yang terdapat permukaan daun tersebut. Sterilisasi lebih komprehensif untuk membunuh berbagai mikroorganisme yang hidup di permukaan daun dilakukan dengan merendam daun dalam etanol 70 % dan NaOCl 3,5 %. Untuk memastikan bahwa mikroorganisme di permukaan daun tersebut telah mati, maka daun ditempelkan di atas media PDA yang berfungsi sebagai kontrol negatif. Daun selanjutnya dipotong berukuran 1 × 1 cm dan dii-nokulasi di atas media agar PDA. Pemotongan daun tersebut bertujuan untuk memudahkan jamur endofitik berpindah dari dalam jaringan daun ke media padat PDA. Sementara itu, penambahan antibiotik bertujuan untuk mencegah tumbuhnya bakteri pada kultur tersebut. Setelah tujuh hari waktu inkubasi, jamur yang tumbuh dipindahkan ke media agar PDA lainnya sehingga diperoleh isolat tunggal jamur endo-fitik dengan kode D-1 (Gambar 1). Pengamatan morfologi secara makroskopik menunjukkan bahwa jamur D-1 mempu nyai warna koloni putih dengan bentuk serabut serta membentuk koloni yang memusat. Permukaan koloni jamur D-1 halus dan tersebar merata ke semua permukaan media. Ja-
Tabel 2: DATA ZONA HAMBAT EKSTRAK ETOAC JAMUR C. gloeosporioides
|
Konsentrasi |
Zona Hambat (mm) | |||
|
E. faecalis |
S. saprophyticus |
S. enterica |
C. freundii | |
|
1% |
6,3 ± 0,6 |
4,3 ± 0,6 |
8,3 ± 0,6 |
4,7 ± 0,6 |
|
3% |
7,7 ± 1,1 |
9,3 ± 0,6 |
12,0 ± 1,0 |
8,7 ± 0,6 |
|
5% |
11,0 ± 1,0 |
12,0 ± 1, |
14,3 ± 0,6 |
12,7 ± 0,6 |
|
Ciprofloxacin 5g/mL (+) |
16,3 ± 0,6 |
17,3 ± 1,1 |
18,3 ± 0,6 |
18,3 ± 0,6 |
mur dengan kode D-1 tersebut selanjutnya diidentifikasi secara genetika menggunakan primer ITS 4: 5‘– TCC TCC GCT TAT TGA TAT GC – 3‘ dan primer ITS 5: 5‘–GGA AGT AAA AGT CGT AAC AAG G –3‘. Hasil identifikasi menunjukkan bahwa jamur D-1 merupakan Colletotrichum gloeosporioides dengan tingkat kemiripan sekuens DNA sebesar 100 %.
Jamur C. gloeosporioides difermentasi skala kecil untuk menentukan waktu optimum jamur tersebut menghasilkan metabolit sekunder. Esktrak EtOAc jamur C. gloeosporioi-des pada masing-masing minggu pertama, kedua, ketiga dan keempat dianalisis massa komulatif metabolit sekundernya untuk mendapatkan infromasi terkait waktu kultivasi optimum. Jamur akan menghasilkan metabolit sekunder pada fase stasioner, yaitu fase dimana terjadinya keseimbangan laju pertumbuhan dan kematian sel. Fase ini terjadi ketika jamur kehabisan nutrisi yang terdapat pada media. Hal ini akan mendorong berbagai enzim yang mempunyai peran dalam sintesis metabolit sekunder terakumulasi sehingga produksi metabolit sekunder akan meningkat secara signifikan (Calvo et al., 2002). Hasil optimasi menunjukkan bahwa dua minggu adalah waktu optimum jamur C. gloeosporioides menghasilkan metabolit sekunder (Tabel 1). Selanjutnya jamur C. gloeosporioides dikultivasi skala besar ke dalam 20 Erlenme-yer yang media cair PDB dengan tujuan memperoleh ekstrak dalam massa yang lebih banyak. Setelah dikultivasi selama tahap stasioner (dua minggu), jamur C. gloeosporioides dipanen dan diekstraksi cair-cair menggunakan etil asetat. Pelarut hasil ekstraksi diuapkan sehingga diperoleh ekstrak pekat EtOAc.
Ekstrak EtOAc tersebut kemudian diuji sifat sitotoksiknya terhadap sel murin leukemia P-388 sebanyak satu kali (Sahi-din et al., 2005). Hasil uji untuk ekstrak terhadap sel murin leukemia P-388 diklasifikasikan menjadi tiga kategori: cukup aktif (IC50 100-500 g/ml), aktif (IC50 10-100 g/ml) dan sangat aktif (IC50 <10 g/ml) (Sirait & Setyaningsih, 2019). Hasil uji (Tabel 3) menunjukkan bahwa ekstrak jamur C. gloeospo-rioides bersifat aktif dengan nilai IC50 sebesar 18,97 µg/mL. Selanjutnya uji aktivitas antibakteri dilakukan terhadap ekstrak EtOAc mengikuti metode difusi cakram (Riga et al., 2019c). Empat jenis bakteri digunakan untuk mengidentifi-
Tabel 3: DATA IC50 SEL MURIN LEUKEMIA P-388
Sampel IC50
EtOAc extract 18,97 µg/mL
Artonin E (+) 0,63 µg/mL
kasi aktivitas antibakteri ekstrak EtOAc jamur C. gloeospo-rioides adalah E. faecalis, S. saprophyticus, S. enterica, and C. freundii. Ekstrak diujikan dalam tiga variasi konsentrasi, yaitu 1 %, 3 % dan 5 %. Uji aktivitas antibakteri ini dilakukan secara triplo dan hasil uji dinyatakan sebagai zona hambat. Ciprofloxacin digunakan sebagai kontrol positif pada uji antibakteri ini. Hasil uji antibakteri ekstrak dikelompokkan menjadi tiga, yaitu sangat aktif (zona hambat >19 mm), aktif (zona hambat 15-19 mm), dan moderat (zona hambat <15 mm) (Cha). Data zona hambat ekstrak EtOAc jamur C. gloeosporioides ditampilkan pada Tabel 2.
Data zona hambat pada Tabel 2 menunjukkan bahwa ekstrak EtOAc jamur C. gloeosporioides mempunyai kemampuan (moderat) dalam menghambat pertumbuhan semua bakteri yang diujikan. Peningkatan konsentrasi ekstrak EtOAc berbanding lurus dengan kenaikan zona hambat. Meningkatnya konsentrasi ekstrak mengindikasikan semakin bertambahnya kandungan senyawa aktif sehingga kemampuan ekstrak dalam menghambat pertumbuhan bakteri semakin besar. Hasil positif ekstrak EtOAc terhadap sitotok-sik dan antibakteri menunjukkan adanya kandungan senyawa bioaktif dari beragam golongan pada ekstrak tersebut. Hasil uji skrining fitokimia (Tabel 4) menunjukkan bahwa ekstrak EtOAc mengandung terpenoid, alkaloid dan fenolik. Ketiga kelompok senyawa dari berbagai penelitian sebelumnya menunjukkan beragam aktivitas biologi, termasuk sitotoksik dan antibakteri.
Senyawa turunan alkaloid bersifat sitotoksik dengan mengganggu munculnya mikrotubul pada fase metafase. Hal ini menyebab proses mitosis sel akan terganggu, dan mengakibatkan proliferasi sel kanker terhambat (Pada et al., 2014). Sementara itu, senyawa golongan terpenoid dan steroid memiliki aktivitas sitotoksik dengan menghambat pertumbuhan dan proliferasi sel kanker sehingga menghalangi membatasi migrasi dan invasi sel kanker dan untuk memodulasi pos pemeriksaan kekebalan (Bailly, 2020). Senyawa fenolik mempunyai aktivitas sitotoksik melalui beberapa mekanisme diantaranya menginhibisi aktivitas topoisomerase DNA I/II, menurunkan ROS (reactive oxygen species), meregulasi ekspresi heat shock protein, modulasi jalur apoptosis, men-gaktivasi caspase-9 dan caspase-3, menurunkan ekspresi faktor transkripsi nukleus kappaB (NF-kappaB), mengaktivasi endonuklease, dan menurunkan protein Mcl-1 (Ren et al., 2003).
Metabolit sekunder golongan alkaloid menginhibisi pertumbuhan bakteri dengan cara mengganggu komponen penyusun peptidoglikan pada sel bakteri. Sedangkan mekanisme senyawa golongan terpenoid dan steroid dalam penghambatan pertumbuhan bakteri dengan cara mengganggu proses pembentukan membran atau dinding sel sehingga din-
Tabel 4: UJI KANDUNGAN METAB OLIT SELUNDER EKS TRAK ETOAC JAMUR C. gloeosporioides
|
Uji Kandungan Metabolit Sekunder |
Hasil Uji |
Keterangan |
|
Terpenoid |
Warna merah |
+ |
|
Alkaloid | ||
|
Dragendorf |
Endapan coklat |
+ |
|
Mayer |
Endapan putih |
+ |
|
Wagner |
Endapan jingga |
+ |
|
Fenolik |
Warna merah muda |
+ |
ding atau membran sel tidak akan terbentuk secara sempurna (Kurniawan & Ferly Aryana, 2015). Sifat antibakteri senyawa fenolik dipengaruhi oleh lipofilisitas, sifat elektronik dan muatan polifenol yang mampu menghambat kerja enzim reverse transkripsi dan DNA topoisomerase (Bouarab-Chibane et al., 2019; Kursia et al., 2018). Penelitian terkait senyawa yang berkontribusi positif terhadap aktivitas antibakteri dan sitotoksik perlu dilanjutkan secara komprehensif.
Hasil uji sitotoksik dan antibakteri dari ekstrak EtOAc jamur endofitik C. gloeosporioides yang diisolasi dari daun A. heterophyllus menunjukkan bahwa ekstrak EtOAc tersebut memiliki kemampuan sitotoksik terhadap sel murin leukemia P-388 serta mempunyai potensi dalam menghambat pertumbuhan bakteri E. faecalis, S. saprophyticus, S. enterica, and C. freundii.
Penulis mengucapkan terima kasih kepada Kementerian Riset, Teknologi dan Pendidikan Tinggi Republik Indonesia melalui Beasiswa Pendidikan Magister menuju Doktor untuk Sarjana Unggul (PMDSU) atas bantuan dana pendidikan dan penelitian yang telah diberikan.
(????).
Achmad, S. A., Hakim, E. H., Makmur, L., Mujahidin, D., Juliawaty, L. D., & Syah, Y. M. (2002). Discovery of Natural Products from Indonesian Tropical Rainforest Plants: Chamodiversity of Artocarpus(Moraceae). Biodiversity, (pp. 91–99).
Bailly, C. (2020). Anticancer Activities and Mechanism of Action of Nagilactones, a Group of Terpenoid Lactones Isolated from Podocarpus Species. Nat. Products Bioprospect., 10(6), 367–375.
Bouarab-Chibane, L., Forquet, V., Lantéri, P., Clément, Y., Léonard-Akkari, L., Oulahal, N., Degraeve, P., & Bordes, C. (2019). Antibacterial properties of polyphenols: Characterization and QSAR (Quantitative structure-activity relationship) models. Front. Microbiol., 10(APR).
Calvo, A. M., Wilson, R. A., Bok, J. W., & Keller, N. P. (2002). Relationship between Secondary Metabolism and Fungal Development. Microbiol. Mol. Biol. Rev., 66(3), 447 LP – 459.
Daus, M., Chaithada, P., Phongpaichit, S., Watanapokasin, R., Carroll, A. R., & Mahabusarakam, W. (2017). New
prenylated dihydrochalcones from the leaves of Artocar-pus elasticus. Phytochem. Lett., 19, 226–230.
Jagtap, U. B., & Bapat, V. A. (2010). Artocarpus: A review of its traditional uses, phytochemistry and pharmacology. J. Ethnopharmacol., 129(2), 142–166.
Khiralla, A., Spina, R., Varbanov, M., Philippot, S., Lemie-re, P., Slezack-Deschaumes, S., André, P., Mohamed, I., Yagi, S. M., & Laurain-Mattar, D. (2020). Evaluation of antiviral, antibacterial and antiproliferative activities of the endophytic fungus curvularia papendorfii, and isolation of a new polyhydroxyacid. Microorganisms, 8(9), 1–20.
Kurniawan, B., & Ferly Aryana, W. (2015). Cassia Alata L) For Inhibiting The Growth Of Bacteria. Escherichia Coli J Major. |, 4, 101.
Kursia, S., Aksa, R., & Nolo, M. M. (2018). Potensi An-tibakteri Isolat Jamur Endofit dari Daun Kelor (Moringa oleifera Lam.). Pharmauho J. Farm. Sains, dan Kesehat., 4(1), 30–33.
Manganyi, M. C., & Ateba, C. N. (2020). Untapped potentials of endophytic fungi: A review of novel bioactive compounds with biological applications. Microorganisms, 8(12), 1–25.
Manoharachary, C., & Nagaraju, D. (2016). Endophytic hyphomycetous fungi associated with some medicinal plants from Telangana state, India. Indian Phytopathol., 69(2), 169–172.
Pada, M., Kanker, S. E. L., & Rahim, L. (2014). CYTOTOXIC ACTIVITY OF ETHANOLIC EXTRACT OF Persea americana Mill . LEAVES ON HeLa CERVICAL CANCER CELL. 19(January), 24–28.
Patil, R. H., Patil, M. P., & Maheshwari, V. L. (2016). Bioactive Secondary Metabolites From Endophytic Fungi: A Review of Biotechnological Production and Their Potential Applications. Stud. Nat. Prod. Chem., 49, 189–205.
Qu, H. R., Yang, W. W., Zhang, X. Q., Lu, Z. H., Deng, Z. S., Guo, Z. Y., Cao, F., Zou, K., & Proksch, P. (2020). Antibacterial bisabolane sesquiterpenoids and isocoumarin derivatives from the endophytic fungus Phomopsis pruno-rum. Phytochem. Lett., 37(November 2019), 1–4.
Ranasinghe, R. A., Maduwanthi, S. D., & Marapana, R. A. (2019). Nutritional and Health Benefits of Jackfruit (Ar-tocarpus heterophyllus Lam.): A Review. Int. J. Food Sci., 2019.
Ren, W., Qiao, Z., Wang, H., Zhu, L., & Zhang, L. (2003). Flavonoids : Promising AnticancerAgents. 23(4), 519– 534.
Riga, R., Happyana, N., & Hakim, E. (2019a). Chemical Constituents of Pestalotiopsis microspora HF 12440. J. Appl. Pharm. Sci., 9(1).
Riga, R., Happyana, N., & Hakim, E. (2019b). Sesquiterpenes produced by Pestalotiopsis microspora HF 12440 isolated from Artocarpus heterophyllus. Nat. Prod. Res..
Riga, R., Happyana, N., Quentmeier, A., Zammarelli, C., Kayser, O., & Hakim, E. (2019c). Secondary metabolites from Diaporthe lithocarpus isolated from Artocarpus heterophyllus. Nat. Prod. Res..
Sahidin, Hakim, E. H., Juliawaty, L. D., Syah, Y. M., Din, L. B., Ghisalberti, E. L., Latip, J., Said, I. M., & Achmad, S. A. (2005). Cytotoxic properties of oligostilbenoids from the tree barks of Hopea dryobalanoides. Zeitschrift fur Naturforsch. - Sect. CJ. Biosci., 60(9-10), 723–727.
Sirait, P. S., & Setyaningsih, I. (2019). Aktivitas antikanker ekstrak Spirulina yang dikultur pada media walne dan media organik. Php, 22(1), 50–59.
Yu, G., Sun, Z., Peng, J., Zhu, M., Che, Q., Zhang, G., Zhu, T., Gu, Q., & Li, D. (2019). Secondary Metabolites Produced by Combined Culture of Penicillium crustosum and a Xylaria sp. J. Nat. Prod., 82(7), 2013–2017.
RIGA DAN HAKIM
198
Discussion and feedback